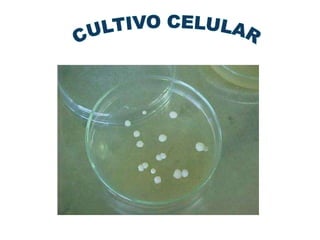

Este documento describe varias técnicas de estudio celular, incluyendo el microscopio óptico, microscopio electrónico de transmisión, microscopio electrónico de barrido, cultivo celular, técnicas inmunológicas como ELISA, cromatografía de intercambio iónico, electroforesis, centrifugación y separación por sedimentación en gradiente de sacarosa. Explica los principios, partes y aplicaciones de cada técnica.